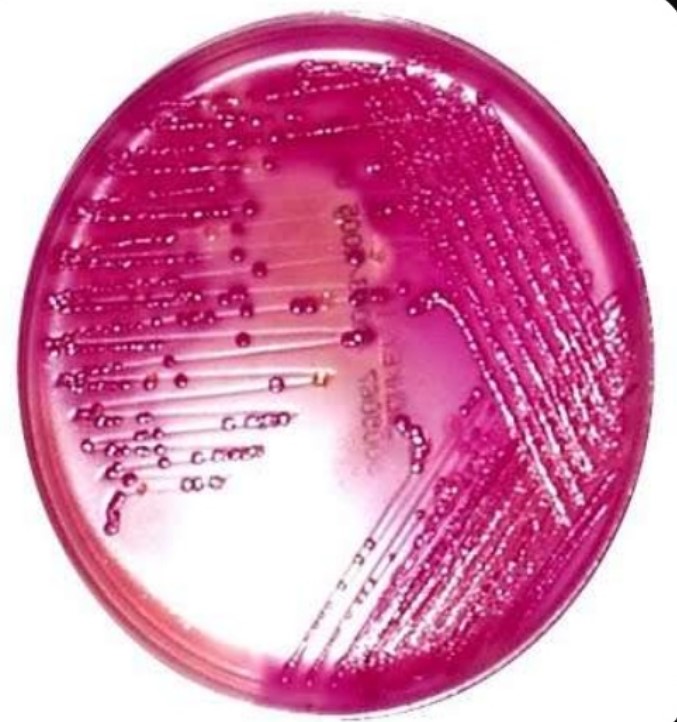

최근에 더치커피에서 오염균으로 알려져 있는 대장균(Escherichia coli, E. coli)가 많이 나와서 판매중단 뉴스가 있었다. 이 뉴스를 보니 대장균이 식약처의 허용기준이 1000 CFU/ml보다 1만4천배인 1400만CFU/ml 가 검출되었다는 이야기가 나온다.
일단 두가지가 이상하지 않은가?
첫번째로는 오염균으로 알려져 있는 대장균이 하나도 없어야 하는데 왜 식약처 허용기준은 1000 CFU/ml 미만으로 되어 있는지?
두번째로는 왜 기준이 1, 10, 51, 932 등 이런 숫자가 아니라 1000 으로 딱 떨어지는지?
이건 우리가 먹는 음식의 오염균 검사의 방법적인 한계? 때문에 저런식으로 표시하는것으로 보인다. 의학에서도 소변검사를 할 때 더치커피의 오염균 검사방법과 비슷한 방법으로 한다.
방광염등 소변에 염증이 있는지 확인을 위해서 하는 요배양검사(urine culture)를 보면,

우선 환자의 소변검체에서 루프를 사용하여 소변검체 일부를 추출하는데, 이때 채취되는 소변양이 약 0.001ml 로 되는 루프를 쓴다. (경우에 따라서는 0.01ml 루프도 있다.)
이후 0.001ml 소변이 묻은 루프를 세균배양을 하기 위한 배지 (보통은 동물의 혈액을 사용함) 에 문질러서 섭씨 35-37도에서 하루나 이틀정도 배양을 한뒤에 배양된 균의 수를 일일이 세는 방법으로 결과를 낸다.
위의 동그란 혈액배지(보통은 blood agar plate, BAP라고 함)에 세균이 자란 동그란 점을 colony forming unit, CFU 라고 이야기하는데, 보통은 이 점 하나는 균 하나에서 발생되어서 나온 것으로 생각하는 것이 타당할것이다.
그럼 0.001ml루프를 사용해서 문지른 혈액배지에 1개의 동그란 점이 생기면 1CFU 가 되고, 이건 0.001ml 에서 자란것이기 때문에 1ml는 1에 1000을 곱한 1000CFU/ml가 되는것이다.
즉 혈액배지에 세균이 하나라도 자라면 소변에 최소한 1000CFU/ml 의 세균이 있다라고 이야기할수가 있는것이다.
만일 세균이 하나도 안자라서 0 CFU가 되었다면 0 CFU/ml 가 되는게 아니라 결과는 최소한 1000CFU/ml 미만으로 있다라고 하는 것이 과학적으로 말을 할 수가 있을것이다.
이런 이유로 아마도 식약처의 오염기준이 1000CFU/ml미만이라고 한 이유는 0.001ml 루프를 사용해서 배지에 문질렀을 때 균이 자라는 점이 하나도 안생기는 기준이 1000CFU/ml 이기 때문에 1000CFU/ml 미만이라고 하면 배지에 하나도 세균이 안자랐다는 의미가 된다.
추가로 방광염의 원인균이 대장균이라고 말을 할때는 위와 같은 방법으로 배지에 100개의 세균이 자란 100CFU 이상이어야 하고, 요배양검사 결과는 >100,000 CFU/ml 라고 표시하게 된다.
위의 내용이 이해가 된다면, 만일 배양검사할 때 0.01ml 루프를 사용한다면 세균이 배지에서 1CFU가 자랐다면 이 균의 결과는 100CFU/ml 가 된다.
어렵게 돌아왔는데, 요약하면 식약처의 허용기준이 1000CFU/ml 미만이라는건 0.001 루프를 사용해서 배지에 배양했는데 균이 하나도 안나온 경우를 이야기하는것이고, 14000000CFU/ml 라는건 그 배지에서 14000 의 세균을 확인했다는 것이다. (개인적으로 14000개를 어떻게 일일이 세었는지는 좀 궁금하다.)




